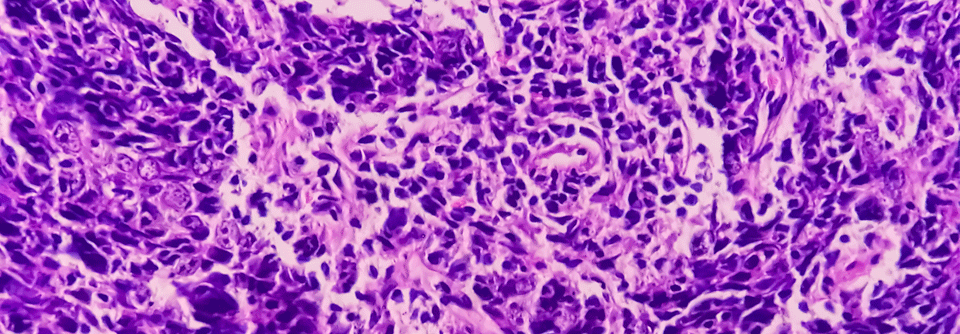

Nasopharynxkarzinom: Toripalimab als neuer Standard?
 Die Addition von Toripalimab verlängert das progressionsfreie Überleben in rezidivierten/metastasierten Tumoren des Nasopharynx.
© Имя Фамилия – stock.adobe.com
Die Addition von Toripalimab verlängert das progressionsfreie Überleben in rezidivierten/metastasierten Tumoren des Nasopharynx.
© Имя Фамилия – stock.adobe.com
Die Kombination Gemcitabin/Cisplatin ist Standard für die Erstlinie des rezidivierten oder metastasierten Nasopharynxkarzinoms (r/mNPC). Ob Patienten von zusätzlichem Toripalimab profitieren, wurde in der Phase-3-Studie JUPITER-02 geprüft. Bereits seit Anfang des Jahres ist der PD1-Antikörper in China auf Grundlage der POLARIS-02-Daten1 für die dritte Linie beim r/mNPC zugelassen.
In JUPITER-02 setzten chinesische Kollegen die Substanz jetzt in der Erstlinie über sechs Zyklen in Kombination mit Gemcitabin/Cisplatin ein und gaben sie danach als Erhaltungstherapie weiter. In der Kontrolle bekamen die Patienten statt Toripalimab jeweils ein Placebo. Primärer Endpunkt war das durch ein…
Bitte geben Sie Ihren Benutzernamen und Ihr Passwort ein, um sich an der Website anzumelden.